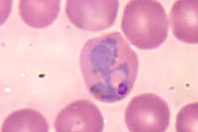
Австралийские ученые выяснили, как малярийному паразиту удается проникать в клетки человека

Перспективы практического применения методов клинической нейрофизиологии | Паломар Х., Исайкин А.И., Свет М.С., Алексеев А.В.
Последние десятилетия отмечены увеличением популярности применения методов доказательной медицины в практическом здравоохранении при выборе тех или иных способов или средств лечения и/или обследования. В то же время расходы на нелекарственные методы лечения, применяемые в неврологии, ортопедии, восстановительной медицине, не только не сокращаются, но продолжают увеличиваться. В последние годы отмечается тенденция к увеличению частоты применения остеопатии,…